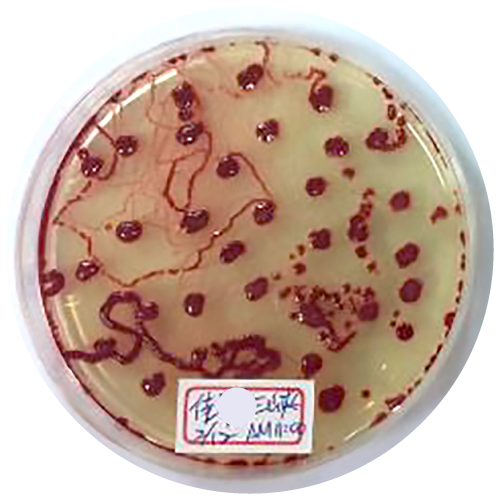
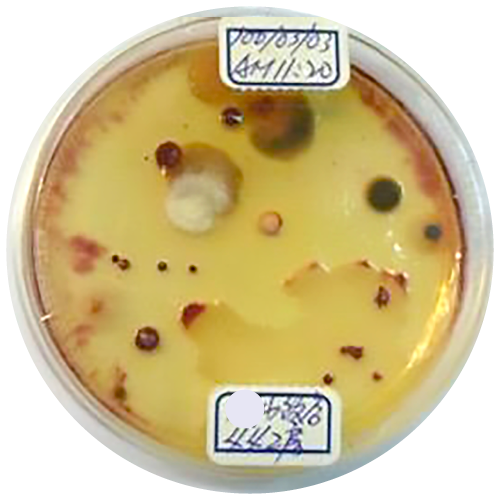
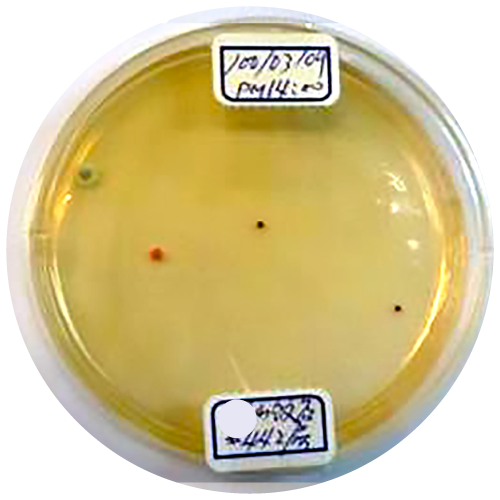
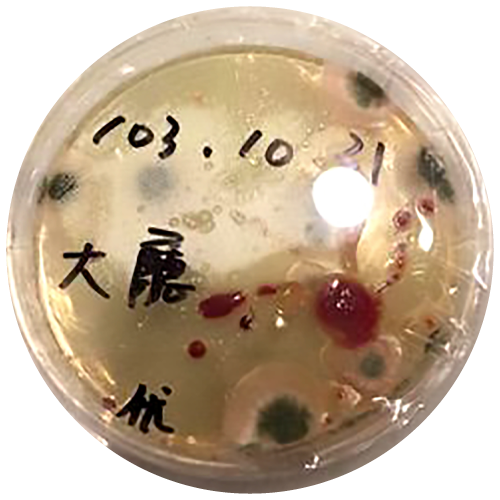
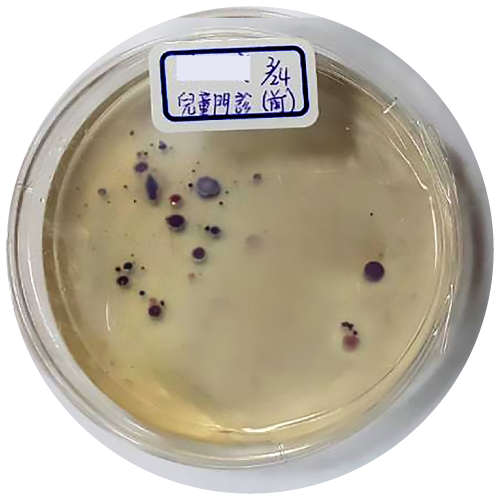
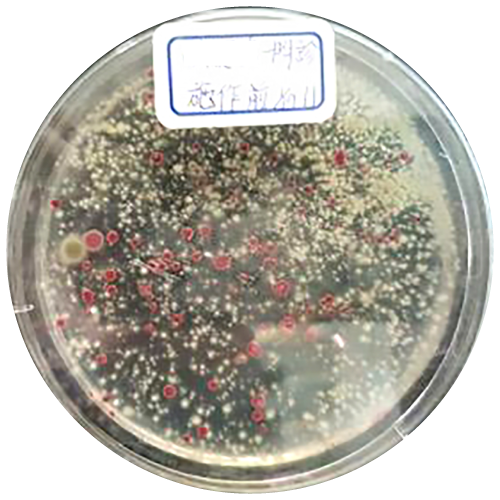

Clean air should not be an added luxury—it is a fundamental necessity.
Five Core Technology Advantages
Active Elimination
Using patented technology, purification agents are released to cover the entire space, actively decomposing pollutants and inactivating viruses. This stops airborne transmission at the early stage, ensuring thorough, corner-to-corner protection.
Safe for Human Coexistence
The purification agents are harmless to humans and can operate continuously in occupied spaces. This enables real-time disinfection without additional protective measures—ideal for environments with long-term human presence.
No Airflow Interference
Disinfection is achieved through natural Brownian motion in the air, without the need for high-speed fans. This prevents accelerated airflow or virus spread, delivering a quiet purification process that preserves indoor comfort.
Maintenance-Free & Low Energy
The system requires no consumables or maintenance, with a service life of up to 25,000 hours. Operating at less than 10 watts, it is energy-efficient, environmentally friendly, and cost-effective over the long term.
Comprehensive Purification
Beyond sterilization, it degrades harmful substances such as formaldehyde, benzene, and TVOCs, while removing odors and particulates. Super-oxidative agents break chemical bonds for highly efficient decomposition of volatile organic compounds.
Business Needs
Air quality is invisible—yet it impacts every aspect of your operations.
Healthcare Facilities
- HEPA filters are passive and cannot cover all dead zones.
- Waiting areas and consultation rooms experience rapid air changes.
- Strict air quality testing requires stable compliance.
- Advanced HVAC systems consume high energy and are complex to maintain.
- Lack of a sustainable, low-consumption, and safe human-coexistence solution.
Long-Term Care Facilities
- Enclosed HVAC systems increase the risk of cross-infection.
- Residents with weaker immunity are highly vulnerable to airborne pathogens.
- Cleaning cannot address airborne microorganisms in real time.
- Odors from waste, humidity, and mold affect care quality perception.
- Traditional purifiers require frequent consumables and costly maintenance.
Educational Institutions
- Crowded classrooms with limited ventilation lead to heavy particles in the air.
- Close contact increases the spread of respiratory illnesses.
- Lingering odors affect focus and concentration.
- Rapid air quality changes outpace slow-responding systems.
- High energy use and filter replacements drive up operational costs.
Restaurants & Central Kitchens
- Oil fumes and food odors often linger in dining areas.
- HVAC and exhaust systems struggle with fine odor molecules.
- Poor air quality affects dining experience and repeat visits.
- Oil particles pose potential respiratory health risks to staff.
- Traditional solutions fail to balance odor control with energy efficiency.
Commercial Offices
- Centralized HVAC causes uneven air quality across workspaces.
- Stale air and odors spread easily throughout entire floors.
- Poor air leads to fatigue, headaches, and allergies, reducing productivity.
- Existing solutions lack real-time response capability.
- ESG goals demand effective air purification strategies.
Residential Spaces
- Poor ventilation leads to accumulation of indoor pollutants.
- Cooking fumes, humidity, and pet odors reduce living comfort.
- Children and the elderly are especially sensitive to air quality.
- Filter-based purifiers require frequent costly replacements.
- Few options exist for long-term, safe, continuous air purification.
Military-Grade Technology
| Function / Feature | ECOHEAL Photocatalytic Electronic Tree | Conventional Home Air Purifiers |
|---|---|---|
| Purification Method | Active photocatalytic ion technology that decomposes pollutants at the source | Passive filter-based system with limited effectiveness |
| Sterilization Capability | High-efficiency sterilization, including decomposition of viruses on surfaces | Basic filtration only, no active pathogen elimination |
| Maintenance Cost | No consumables, no cleaning required; near-zero maintenance cost | Requires regular filter replacement, generating recurring consumable costs |
| Air Quality Performance | Produces pure air while removing odors, sterilizing, and reducing particulates | Limited dust filtration; ineffective against odors and microorganisms |
| Application Standards | Military-grade technology, already deployed in hospitals, long-term care facilities, and restaurants | Designed mainly for everyday household use |
| Market Position | Proprietary patented technology, unique in the market | Numerous brands with inconsistent quality |
| Energy Efficiency | Ultra-low power consumption (7–10W), monthly electricity cost under NT$50 | Generally higher power usage, leading to significant electricity costs |
| Certifications & Evidence | Backed by multiple international test reports, clinical evidence, and safety certifications | Marketing claims often lack sufficient evidence; most lack comprehensive certifications |
Photocatalytic Ion Technology
PSNR™ & PHIT™

Biological Contaminants
Destruction of viruses and bacteria
Purification agents physically disrupt bacterial cell membranes.
Viral DNA/RNA envelopes are dismantled, inactivating pathogens.

Organic Contaminants
Decomposition of air pollutants and odor molecules
Purification agents break chemical bonds through targeted impact.
Organic compounds are reduced to CO₂ and H₂O, returning synthetic organics to nature.

Suspended Particles
Settling of PM2.5 particles
Photocatalytic ions carry electrical charges that attract and aggregate fine particulate matter.
Aggregated particles form larger clusters that settle to the ground, preventing inhalation.
Professional Certification
Passing professional certifications is our baseline standard for quality.
HUAK TESTING
HUAK Testing Certificate
NASA
NASA Brand Authorization
SGS
PM2.5 Removal Efficiency Test Report
SGS
Antibacterial Efficacy Test Report
SGS
Formaldehyde Removal Test Report
SGS
ozone test report
Guangwei Testing
Ozone Detection Report
Guangwei Testing
Air Purification Efficiency Report
On-Site Testing
Sampling was conducted using internationally standardized air samplers: 5 minutes per 15 liters of air.
Impaction sampling plates were then incubated in a controlled environment at 30°C and 60% humidity for 48 hours.
Results:
- Bacteria, mold, and viruses were effectively eliminated.
- Under the protection of ECOHEAL air purification systems, the PHIT™ technology demonstrated a sterilization efficacy of up to 99%.
This on-site testing provides empirical evidence of ECOHEAL’s high-performance sterilization capability in real-world environments.
Use Case of New Taipei City OO Public Elderly Care Center

Taipei OO Hotel Use Case

Taipei OOO Postpartum Nursing Home Use Case

New Taipei OO public nursing home case

Taipei OO Hospital Use Case

Products at a Glance
Product Overview

Product Name
Car type
Model
ARC
Coverage Area
-
Net Weight
About 90 g
Dimensions
L77 × W86 × H51 (mm)
Input Power
DC12V / 500mA
Output Power
-
Power Consumption
<2W
Material
PC/ABS
Country of Manufacture
Taiwan
EAN-13
4710243660010
Operating Temperature
-10~45℃
Storage Temperature
-20~70℃
Certifications & Test Reports
CQC
CNAS
SGS – Airborne Bacteria Removal Efficiency Test
SGS – Particulate Matter (PM2.5) Filtration Test
SGS – Formaldehyde Removal Test
SGS – Ozone Detection Report

Product Name
Car type
Model
ARC II
Coverage Area
3–10 m² | 1–3 pings |
Approximately 32–106 sqft
Net Weight
125 g
Dimensions
L95 × W95 × H32 (mm)
Input Power
DC5V 1.5A
Output Power
-
Power Consumption
<4W
Material
PC/ABS
Country of Manufacture
Taiwan
EAN-13
4710243660102
Operating Temperature
-10~45℃
Storage Temperature
-
Certifications & Test Reports
SGS Air Bacteria Removal Test, SGS Dust Removal Test (PM2.5), SGS Formaldehyde Removal Test, SGS Ozone Test Report

Product Name
Home use
Model
BM6
Coverage Area
20–50 m² | 7–15 pings |
Approximately 215–538 sqft
Net Weight
0.75 kg
Dimensions
L82 × W132 × H250 (mm)
Input Power
AC 100-240V 50/60Hz
Output Power
12V/2A
Power Consumption
AC 0.3A / 10W
Material
-
Country of Manufacture
Taiwan
EAN-13
4710243660003
Operating Temperature
-10~45℃
Storage Temperature
-20~70℃
Certifications & Test Reports
CQCCNASBSMI No.: R36235SGS Dust Removal Test ReportSGS Formaldehyde Removal Test ReportSGS Total Volatile Organic Compounds Removal Test ReportTaiwan Power Research and Testing Center Ozone Test ReportMing-Chi University of Science and Technology Staphylococcus aureus Extinction Test ReportGuangdong Microbiology Analysis and Testing Center Sterilization Test ReportGuangdong Microbiology Analysis and Testing Center TVOC Test ReportGuangdong Microbiology Analysis and Testing Center PM2.5 Test ReportGuangdong Microbiology Analysis and Testing Center Ozone Concentration Test Report

Product Name
Public type
Model
PRO 9
Installation Method
Screw wall mount
Component Irradiance
20mw or more
Component Material
High transmittance quartz glass (transmittance 99.9%)
Coverage Area
33–132 m² | 10–40 pings |
Approximately 355–1,421 sqft
Safety Features
The ballast temperature exceeds 80 degrees and the power is automatically cut off.
Net Weight
Net. 3.5 kg / Box 4 kg
Dimensions
Main unit L450×W165×H82.5(mm) Stand L40×W40×H40(mm)
Input Power
AC 110V ~ 220V50Hz/60Hz
Output Power
DC 2A
Power Consumption
12W
Material
Galvanized steel plate paint
Country of Manufacture
Taiwan
EAN-13
-
Operating Temperature
-
Storage Temperature
-
Certifications & Test Reports
CQCCNAS

Product Name
Commercial
Model
PRO 17
Installation Method
Screw wall mount
Component Irradiance
20mw or more
Component Material
High transmittance quartz glass (transmittance 99.9%)
Coverage Area
150–300 m² | 50–100 pings |
Approximately 1,614–3,229 sqft
Safety Features
The ballast temperature exceeds 80 degrees and the power is automatically cut off.
Net Weight
Net. 7.6 kg / Box 8 kg
Dimensions
Main unit L220×W110×H600(mm); including base plate L320×W150×H650(mm); base plate diameter L320×W320×H150(mm); outer box L460×W260×H660(mm)
Input Power
AC 110V or 220V50Hz/60Hz (none Switch)
Output Power
AC 0.3A / DC 2A
Power Consumption
40W
Material
Galvanized steel plate paint
Country of Manufacture
Taiwan
EAN-13
4710243660096
Operating Temperature
-
Storage Temperature
-
Certifications & Test Reports
CQCCNAS

Product Name
Engineering
Model
IAQ9
Installation Method
-
Component Irradiance
-
Component Material
-
Coverage Area
30–132 m² | 10–40 pings |
Approximately 323–1,421 sqft
Safety Features
-
Net Weight
-
Dimensions
L320×W81×H47 including base plate (mm)
Input Power
-
Output Power
-
Power Consumption
-
Material
-
Country of Manufacture
Taiwan
EAN-13
-
Operating Temperature
-
Storage Temperature
-
Certifications & Test Reports
-
FAQ
FAQ
Q01. Please briefly introduce EcoHeal’s PHIT™ Photosynthetic Ion Purification Technology.
PHIT™ technology replicates natural environmental transformation mechanisms within indoor spaces. By simulating the interaction of light, air, and moisture, EcoHeal functions like a “mini indoor sun,” enabling continuous, low-energy, and natural air purification.Q02. If pets are kept indoors, will EcoHeal easily attract pet hair and dander?
EcoHeal is designed as a desktop unit and is recommended to be placed on elevated surfaces to enhance air circulation. Compared to floor-standing devices, it is less likely to attract pet hair or dander that accumulates near the ground.Q03. Why does EcoHeal’s photosynthetic ionization not cause the “black wall effect”?
EcoHeal generates only mildly charged purification ions that attach to airborne particles, increasing their mass so they settle naturally by gravity. This prevents particles from adhering to walls or human bodies. In contrast, high-voltage negative ion systems generate highly charged static particles that redeposit contaminants on surrounding surfaces, causing the black wall effect.Q04. Why does the EcoHeal+ broadband UV light not harm human skin? How does it differ from other PHI or PHIT™ technologies on the market?
Conventional UV disinfection lamps are often open-type systems that emit direct radiation into the environment, potentially causing skin damage. EcoHeal+ incorporates a patented reflective chamber design that prevents direct exposure, with measured emissions at only one-tenth of established safety limits. Unlike generic PHI systems, EcoHeal’s PHIT™ technology is based on patented semiconductor-grade light-emitting components manufactured under exclusive specifications to ensure consistency, safety, and performance.Q05. Are there any special placement requirements for desktop use?
Ensure the surface is clean and that no objects obstruct the device. Any blockage may reduce purification efficiency.Q06. What effects do EcoHeal’s purification factors have on household pets?
The purification factors help decompose pet odors, inhibit bacteria on the skin, reduce the risk of skin conditions, and block cross-contamination of bacteria and viruses between pets and humans.Q07. Are there side effects when EcoHeal operates continuously in enclosed spaces? Will concentrations accumulate over time?
Most residential and commercial spaces are semi-enclosed with ongoing air exchange. The substances generated by EcoHeal are identical to natural byproducts found in outdoor and forest environments. They do not accumulate, cause side effects, or pose health risks to humans.Q08. What is a photosynthetic reaction, and how does EcoHeal replicate natural phenomena?
Inspired by natural photosynthesis in trees and rainforests, EcoHeal’s PHIT™ Photo-Hydrated Ion Technology simulates the interaction of light, water, and oxygen to convert oxygen into advanced air purification factors, enabling continuous, natural, and energy-efficient indoor air circulation and purification.Q09. Will long-term use of EcoHeal cause carbon dioxide or other gases to accumulate indoors?
The amount of carbon dioxide produced after the reaction is extremely minimal and does not accumulate. As the system does not rely on high-voltage discharge, it does not generate harmful secondary gases.Q10. Will dry air in air-conditioned environments affect EcoHeal’s performance?
No. Air-conditioning systems typically maintain relative humidity around 60–65%, which is sufficient for stable PHIT™ reactions and does not affect performance.Q11. What are “purification factors,” and how do they differentiate between pathogens and humans?
Purification factors are mildly charged ionized particles generated through photosynthetic reactions. They selectively deactivate viruses and bacteria by disrupting their structures, while remaining non-reactive to the human body. When inhaled, they help reduce pollutants in the respiratory tract and lower irritation.Q12. Are settled particles dangerous if touched or stepped on?
No. Settled particles are simply dust and can be safely wiped away or vacuumed. The true health risk comes from airborne PM2.5, PM10, and ultrafine particles that can penetrate deep into the body when inhaled.Q13. Will hydrogen peroxide or other gases accumulate in enclosed spaces? Is ventilation required?
EcoHeal produces hydrogen peroxide—not ozone—which is a naturally occurring substance. Continuous operation is safe, and shutdown is unnecessary. Ventilation is recommended primarily to replenish oxygen and moisture required for optimal reactions. Selecting the appropriate model ensures stable output without accumulation risks.Q14. If windows are not opened for extended periods, will EcoHeal’s effectiveness decline?
Opening windows supports basic air exchange to remove indoor carbon dioxide and replenish oxygen and moisture, which benefits overall health. Any increase in purification performance is an added benefit.Q15. How long does it take EcoHeal to reduce formaldehyde levels in a 10-ping (~33 m²) space?
Air purification performance depends on complex environmental variables and cannot be precisely quantified without standardized conditions. However, testing demonstrates that PHIT™ technology is highly effective in decomposing formaldehyde. Given formaldehyde’s long half-life of 15–20 years, long-term continuous use is recommended.Q16. Why choose EcoHeal if an air purifier is already installed?
Traditional air purifiers are limited by airflow dynamics and filter efficiency, making it difficult to treat all air within a space. EcoHeal provides 3D, 360-degree, whole-room purification that complements and enhances conventional filtration systems.Q17. Will EcoHeal’s purification factors be removed by other air purifiers operating simultaneously?
No. Instead, they assist filtration-based devices by decomposing contaminants trapped on filters, inhibiting microbial growth, and extending filter lifespan.Q18. Can EcoHeal help reduce dust mites? Will it harm humans?
EcoHeal reduces dust mite populations by limiting microbial spores that serve as food sources for larvae. It also purifies the skin surface, achieving dual benefits without posing any risk to human health.Q19. If a person carrying COVID-19 on their body surface enters a space where EcoHeal operates 24/7, how long does it take to deactivate the virus?
The reaction is immediate upon contact between purification factors and the virus. However, EcoHeal is not a medical treatment device and cannot affect viruses that have already entered the human body.Q20. If an asymptomatic COVID-19 carrier exhales virus-laden air, how long does EcoHeal take to purify it?
The reaction is immediate. Airborne viruses begin to be deactivated upon contact with the purification factors, reducing the risk of cross-infection.Q21. During severe dust storms, what additional benefits does EcoHeal provide beyond HEPA filtration?
EcoHeal enables full-room particle settlement through 3D/360-degree release of purification factors, increasing particle mass so they settle by gravity and reducing inhalation risks beyond conventional HEPA filtration alone.Q22. Can portable UV-based EcoHeal products cause genetic or biological damage if the light source is visible?
EcoHeal portable models incorporate reflective shielding and indirect refraction to prevent energy leakage. The visible light emitted is low-energy blue light and is generally harmless. However, prolonged direct viewing of the light source is not recommended to protect eye health.
Article Sharing
Articles & Insights

© Copyright
ECOHEAL























